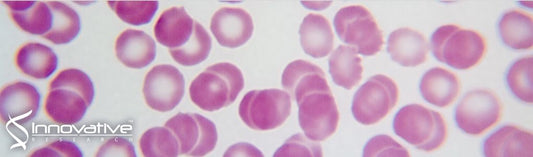
Cathelicidin Peptides Restrict Bacterial Growth via Membrane Perturbation and Induction of Reactive Oxygen Species

Product References
Cathelicidin Peptides Restrict Bacterial Growth via Membrane Perturbation and Induction of Reactive Oxygen Species
Single Donor Human Red Blood Cells from Innovative Research was used in the following study: Cathelicidin Peptides Restrict Bacterial...
Coupling Fluorescence-Activated Cell Sorting and Targeted Analysis of Histone Modification Profiles in Primary Human Leukocytes
Single Donor Human Buffy Coats Leukocytes from Innovative Research was used in the following study: Coupling Fluorescence-Activated Cell Sorting...
Reduction of Blood Volume Required to Perform Paper-Based Hematocrit Assays Guided by Device Design
Single Donor Human Red Blood Cells Washed from Innovative Research was used in the following study: Reduction of Blood...